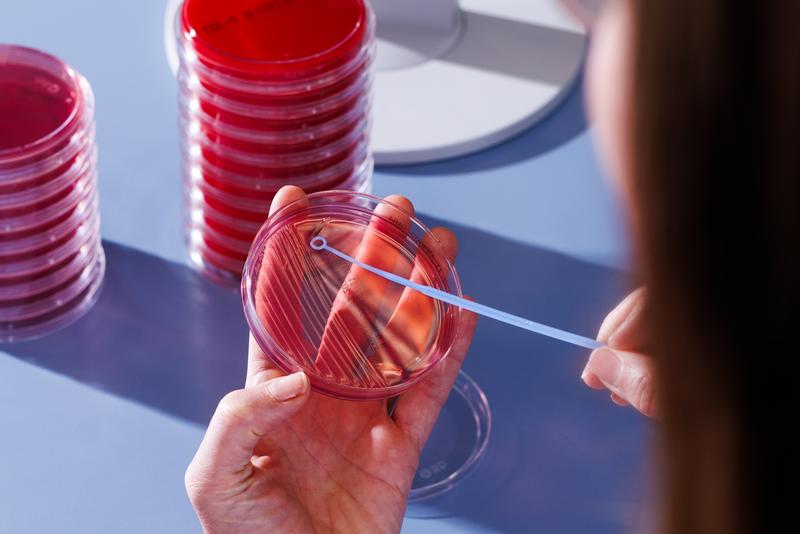
Bild von Mikrobiologie

Einzelne Analysen können wir nicht bei uns im Labor durchführen. Damit die hohen Anforderungen an eine optimale Qualität stets gewährleistet sind, werden diese Analysen an spezialisierte Partnerlaboratorien vergeben. Bei diesen Analysen ist auf dem Befund der erste Buchstabe fett gedruckt. Im Analysenverzeichnis sind diese Analysen dadurch gekennzeichnet, dass bei der Rubrik «Labor» der Begriff «Extern» (inkl. Zahlencode) ersichtlich ist. Angaben zum Unterauftragnehmer für eine bestimmte Analyse können bei uns erfragt werden.
Wir arbeiten mit folgenden Unterauftragnehmern zusammen:
(1001) ANALYTICA AG / Labor Spital Affoltern (STS 0386)
(1016) CHUV Laboratoire des Catécholamines et Peptides Réception des Laboratoires BH-100, 1011 Lausanne
(198) CHUV Service d’immunologie et d’allergie Laboratoire de diagnostic, 1011 Lausanne (SMTS 0012)
(220) Dr. Risch, 3097 Liebefeld-Bern (STS 0177)
(166) HUG Hôpitaux universitaires de Genève, (Laboratoire de Virologie) 1211 Genève (SMTS 0032)
(1024) HUG Hôpitaux universitaires de Genève, (Laboratoire d’Hémostase) 1211 Genève (SMTS 0032)
(211) Institut für Infektionskrankheiten der Universität Bern, Abt für Klinische Mikrobiologie, 3010 Bern (SMTS 0114)
(1009) Institut für Lebensmittelsicherheit und -hygiene ILS der Universität Zürich NENT, 8057 Zürich (STS 0100)
(144) Institut für Medizinische Mikrobiologie der Universität Zürich (Diagnostik), 8006 Zürich (SMTS 0105)
(197) Institut für Medizinische Virologie der Universität Zürich, Diagnostik, 8057 Zürich (SMTS 0098)
(132) Institut für Parasitologie Universität Zürich, 8057 Zürich (STS 0346)
(155) Institut für Virologie und Immunologie IVI Tollwutzentrale, 3001 Bern (STS 0624)
(149) Interregionale Blutspende SRK AG, Murtenstrasse 133 in 3001 Bern (STS 0371)
(1003) Labor Team AG, 9403 Goldach
(165) Laboratoire MGD, 1204 Genève
(147) Laborgemeinschaft 1 Medizinisches Labor, 8047 Zürich
(1018) Luzerner Kantonsspital Pathologisches Institut 6000 Luzern (SMTS 0103)
(1021) Luzerner Kantonsspital Labormedizin Haus 31 6000 Luzern 16 (STS 0461)
(173) MCL Medizinische Laboratorien, 3172 Niederwangen b. Bern (STS 0257)
(154) Medics Labor AG, 3001 Bern (SMTS 0106)
(1010) Ospedale Regionale Bellinzona e Valli, 6500 Bellinzona (SMTS 0072)
(159) Schweizerisches Tropen- und Public Health-Institut, 4123 Allschwil (STS 0426)
(135) Stadtspital Triemli, Institut für Labormedizin, 8063 Zürich (SMTS 0079)
(1014) Swiss Analysis AG, 8274 Tägerhalde
(195) MEDISYN SA, 6002 Luzern (STS 0156)
(221) Unilabs AG Labor für Medizinische Analytik, 8600 Dübendorf (SMTS 0040)
(160 / 161) Universitätsspital Basel, Labormedizin, 4031 Basel (STS 0568)
(189) Universitätsspital Zürich Dermatologische Klinik, 8952 Zürich (SMTS 0047)
(1005 / 232) Universitätsspital Zürich, Institut für Klinische Chemie, 8091 Zürich (STS 0206)
(182) Universitätsspital Zürich, Institut für Neuropathologie 8091 Zürich
(1007) Universitätsspital Zürich, Klinik für Neurologie 8091 Zürich
(142) Universitätsspital Zürich, Klinik für Medizinische Onkologie und Hämatologie, 8091 Zürich (SMTS 0102)
(143 / 145 / 1004 / 1006) Universitätsspital Zürich, Querschnittsbereich Klinik für Immunologie, 8091 Zürich (SMTS 0071)
(1019) Université de Fribourg, Unité de microbiologie médicale et moléculaire NARA, 1700 Fribourg
(1002) Zentrum für Labormedizin Insel Gruppe AG, 3010 Bern (STS 0259)
(163 / 164) Zentrum für Labormedizin St Gallen, 9001 St Gallen (STS 0155)
(137 / 209 / 140 / 181) Zentrum für Pädiatrische Labormedizin, Universitäts-Kinderspital Zürich, 8032 Zürich (SMTS 0062)
(224) Zürcher Blutspendedienst SRK, 8952 Schlieren (STS 0447)